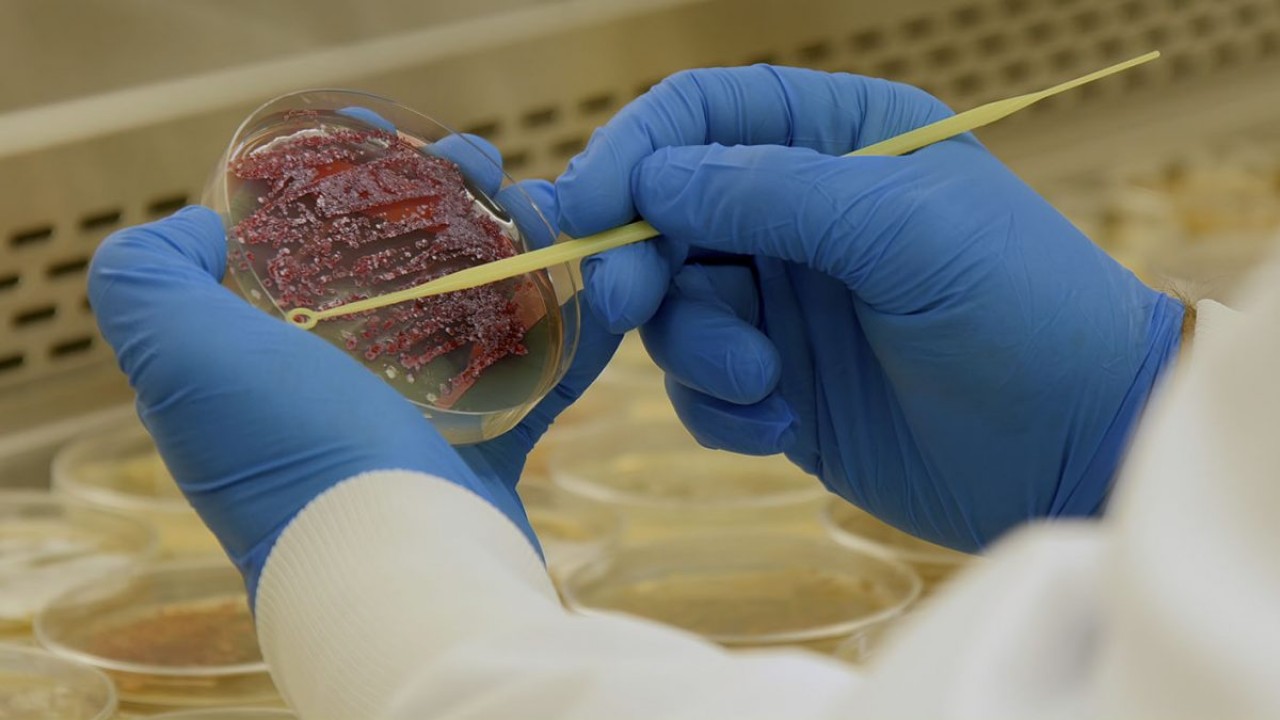
Beating Superbugs: Can We Win?

Watch Beating Superbugs: Can We Win?
- 2021
- 1 hr 7 min
-
0.0 (11)
While the world was consumed with handling COVID-19, bacterial infections also played a deadly role. A look at how we can defeat these bugs.
Beating Superbugs: Can We Win? is a 2021 documentary with a runtime of 1 hour and 7 minutes.